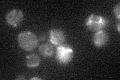
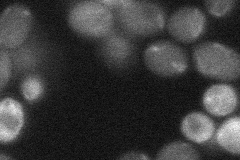
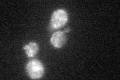

View description
Mitochondrial intermembrane space protein that regulates mitochondrial cardiolipin levels, null has defects in Mgm1p processing, integrity of mitochondrial inner membrane complexes, and mitochondrial morphology; ortholog of human PRELI
Localization:
Intensity:
Fold change:
Significance:
-
C’ GFP library in SD
mitochondria22.82 -
N' NOP1pr-GFP in SD

cytosol,punctate29.2446 -
N' TEF2pr-mCherry in SD

cell periphery,vacuole0 -
N' NATIVEpr-GFP in SD
below threshold25.3708 -
N' TEF2pr-VC and Cyto-VN in SD

#N/A0 -
C’ GFP library in SD+DTT
mitochondria20.30.88No -
C’ GFP library in SD+H2O2

mitochondria21.230.93No -
C’ GFP library in Starvation Media

mitochondria21.340.93No -
C’ GFP library on the background of Pup2-DaMP

mitochondria -
C’ GFP library on the background of CCT mutant

mitochondria21.2440.930808No
